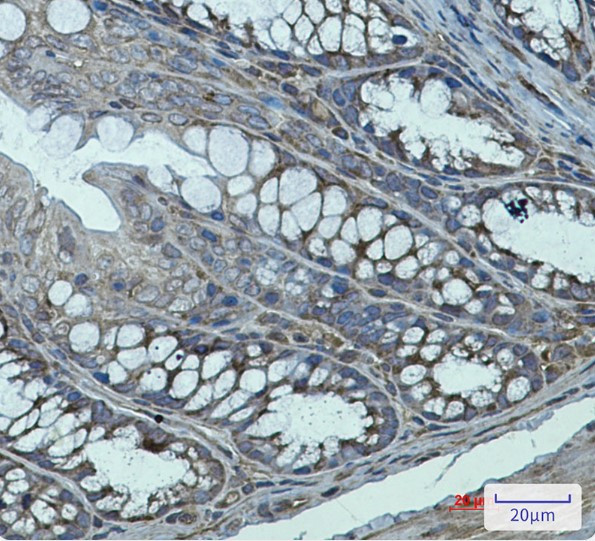
TGM2 Antibody in Immunohistochemistry (Paraffin) (IHC (P))

Search
Abnova
TGM2 Recombinant Rabbit Monoclonal Antibody
{{$productOrderCtrl.translations['antibody.pdp.commerceCard.promotion.promotions']}}
{{$productOrderCtrl.translations['antibody.pdp.commerceCard.promotion.viewpromo']}}
{{$productOrderCtrl.translations['antibody.pdp.commerceCard.promotion.promocode']}}: {{promo.promoCode}} {{promo.promoTitle}} {{promo.promoDescription}}. {{$productOrderCtrl.translations['antibody.pdp.commerceCard.promotion.learnmore']}}
产品信息
RAB01855
种属反应
宿主/亚型
Expression System
分类
类型
抗原
偶联物
形式
纯化类型
保存液
内含物
保存条件
运输条件
靶标信息
Transglutaminase (TGase) catalyses the crosslink of proteins by forming e-(g-glutamyl) lysine isopeptide bonds and requires the binding of Ca2+ for its activity. In mammals, eight distinct TGase isoenzymes have been identified. Tissue transglutaminase (tTGase), also known as TGase 2, has four distinct domains: N-terminal b-sandwich, catalytic core and two C-terminal b-barrel domains. tTGase may have a role in cell death, cell proliferation, cell differentiation, and receptor-mediated endocytosis. In the Alzheimer's disease brain, the elevated tTGase activity is manifested by polymerization of a number of proteins, including Ab peptide, b-amyloid precursor protein and the tau protein, with formation of neurofibrillary tangles.
仅用于科研。不用于诊断过程。未经明确授权不得转售。
篇参考文献 (0)
生物信息学
蛋白别名: C polypeptide; C polypeptide, protein-glutamine-gamma-glutamyltransferase; crosslinker; Erythrocyte transglutaminase; G alpha h; G(h); G-ALPHA-h; GNAH; Heart G alpha(h); hhG alpha(h); Isopeptidase TGM2; Protein G alpha(h); Protein G(h); Protein-glutamine deamidase TGM2; Protein-glutamine dopaminyltransferase TGM2; Protein-glutamine gamma-glutamyltransferase 2; Protein-glutamine histaminyltransferase TGM2; Protein-glutamine noradrenalinyltransferase TGM2; Protein-glutamine serotonyltransferase TGM2; protein-glutamine-gamma-glutamyltransferase; RP5-1054A22.2; TG C; TG(C); TG2; TGase 2; TGase C; TGase H; TGase II; TGase-2; TGase-H; TGC; Tissue transglutaminase; Tissue type transglutaminase; tissue-type transglutaminase; Transglutaminase 2 C polypeptide; transglutaminase 2, C polypeptide; Transglutaminase C; Transglutaminase H; Transglutaminase II; Transglutaminase-2; tTG; tTgase; unnamed protein product
基因别名: G(h); G[a]h; hTG2; TG(C); TG2; TGase2; TgaseII; TGC; TGM2; tTG; tTGas
UniProt ID: (Human) P21980, (Rat) Q9WVJ6, (Mouse) P21981
Entrez Gene ID: (Human) 7052, (Rat) 56083, (Mouse) 21817